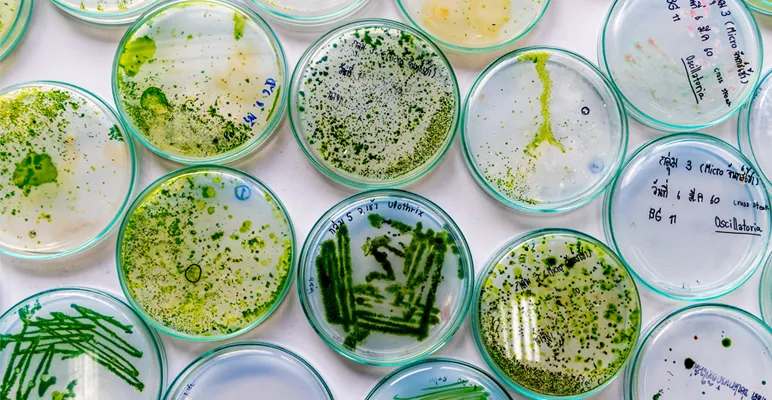
Probiotics:

Our bodies contain just as many microbial cells as human cells, if not more - and most of these microbes are located in our gut. So, what are probiotics and prebiotics, and how can they help maintain gut health?
The microbes that live inside us have important roles to play in keeping us healthy. Nowhere is this truer than in the gut, where microbes contribute not only to digesting our food but also to maintaining gut structure and protecting us from infection.1 Due to the importance of our gut microbiome, both probiotics and prebiotics have gained popularity as tools to help us maintain our gut health and overall well-being - but what are they, and how do they work?
Probiotics: live beneficial microbes

Probiotics are live microorganisms, often bacteria or yeasts, that benefit our gut health when consumed in our food. These microbes, whether acquired naturally from food or from probiotic supplements, settle along the gut. From there, they assist in the digestion of components in our foods, which our own cells find difficult to break down.
Bifidobacteria, for example, are one of the first strains of bacteria to colonise the gut after birth.2 These bacteria then support the growth of a range of other microbes, which strengthen the gut’s structure for nutrient absorption and create a protective barrier, outcompeting disease-causing strains to reduce the chance of a gut infection. Throughout this struggle for survival, the beneficial microbes in our gut need to fuel themselves - which is where prebiotics come in.
Learn more about probiotics and the science behind good bacteria
Prebiotics: food for microbes

There are certain parts of our food that we can’t digest, but that can be fermented and used as fuel by the microbes in our gut. These parts of our food are prebiotics (or fibre). Prebiotics provide microbes with the resources they need to grow and establish themselves in the gut3 - but crucially, prebiotics preferentially encourage the growth of microbes that benefit our health over those that cause disease.4
Find out more about calculating food expiry dates
The most common prebiotics are forms of fibre, such as inulin in bananas or the small-chain carbohydrates known as fructo-oligosaccharides (FOS) and galacto-oligosaccharides (GOS), which are commonly found in a range of fruits and vegetables, especially legumes. Some foods even contain both prebiotics and probiotics, such as kimchi, a spicy fermented Korean dish, or sauerkraut, a European form of fermented cabbage.
Learn more about how kimchi and kombucha are made.
Boosting your intake of probiotics and prebiotics
Put simply, probiotics are live microbes that live in and support our gut function, while prebiotics act as food for those microbes. Both probiotics and prebiotics are naturally present in the food we eat - meaning we can boost our intake by adjusting our diet - but both are also available as health supplements for those who require an alternative source.5
While getting the right balance of both probiotics and prebiotics will help us maintain the number of beneficial microbes in our gut and bring long-term benefits to our gut health, both probiotics and prebiotics may also offer hope as new medical treatments for a range of diseases. For example, taking probiotics has been shown to help protect the gut from infection when taking a course of antibiotics and to help treat the inflammatory bowel disease ulcerative colitis,6. At the same time, research is ongoing to explore prebiotics' roles in protecting the gut from infections like salmonella and even reducing the risk of bowel cancer.7